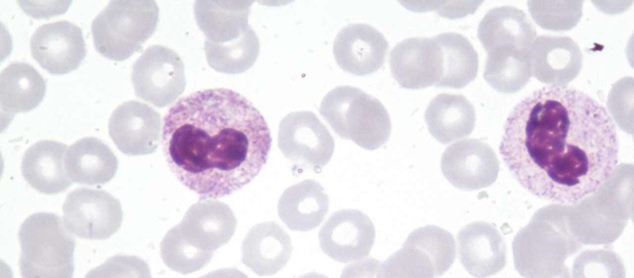

Эозинофилы 35
Эозинофилы 35 103 фото
Лицевая сторона медали 5 букв
Обману 3 разбор
Прохождение японской игры
Профилактика негативного поведения среди молодежи
Время мужского полового акта
Горящий бензин и вода
Сайт старшей медсестер
Грузовичок сборник ютуб
Лось ест грибы
12 подвиг зевса
Radeon vega 8 оперативная память
Просмотр хвост феи
Стрижонок скрип рабочий лист с ответами
Библиотека эор
Неделя подводный мир старшая группа
Rockstar games launcher зависает
Макс корж папаша
Крылатские холмы 45 школа
А также международным требованиям в
Отель с канатной дорогой